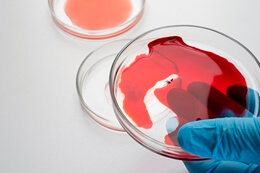
Лечение эритроплазии Кейра в Израиле Лечение эритроплазии Кейра в Израиле

Лечение рака в клиниках Израиля имеет приоритетное значение в связи со стремительным ростом заболеваемости онкологией как в регионе, так и во всем мире. Благодаря современному материально-техническому оснащению онкоклиник и их тесной кооперации с ведущими исследовательскими центрами Европы и Северной Америки израильские онкологи достигли небывалых результатов. Согласно мнениям практикующих врачей, экспертов Всемирной Организации Здравоохранения и отзывам пациентов, методы, применяемые израильскими врачами, помогают больным существенно улучшить качество жизни даже на поздних стадиях заболевания, а процент выздоровевших один из самых высоких в мире.
Обзор клиник (онкологические отделения)
-
- Лучшая частная клиника Тель Авива
- Выбор доктора разрешен
- Повышенный уровень комфорта
- Новейшее оборудование
-
Оценка: 8.8Отправить запрос
- Описание
- Отзывы
- Врачи
-
- Крупнейшая государственная клиника
- Ведущее отделение гематоонкологии
- Комплексный подход
- Современные технологии
-
Оценка: 8.3Отправить запрос
- Описание
- Отзывы
- Врачи
-
Иван Григорьевич, г. Омск
Опухоль предстательной железы мне удаляли с помощью роботизированной установки Да Винчи. Не устаю удивляться, до чего дошел прогресс. Операция обошлась мне в 25000$.
-
Рита Парфенюк
У меня рак желудка. Врачи клиники Шиба использовали малоинвазивный метод операции - лапароскопию, в итоге я после операции встала на ноги за 3 дня.
-
Валерия
В клинике Шиба имеется собственный онкологический центр. Я обратилась сюда для программы онкодиагностики “чек-ап”. Очень довольна, все обследование заняло 2 дня, в больницу ложиться не пришлось.
-
-
Администратор11.10.2019
В клинике Шиба оказывают полноценную паллиативную помощь пациентам с тяжелыми случаями рака. Она включает максимальное обезболивание, применение медикаментов, продлевающих жизнь (биотерапия), снятие симптомов заболевания, психологическую помощь, уход за пациентом. В случае необходимости здесь проводят операции по удалению метастазов и самой опухоли.
-
-
- Центральная больница Тель Авива
- Выбранный доктор не гарантирован
- Международный стандарт JCI
- Сложные операции
-
Оценка: 8.3Отправить запрос
- Описание
- Отзывы
- Врачи
-
Инга
Что такое таргетная терапия?
-
Константин П., г. Казань
На очередной флюорографии в правом легком обнаружили небольшую опухоль. В Ихилов подтвердили, что она злокачественная. Сделали операцию, чем уберегли меня от худшего.
-
Ксения В.
В Ихилов очень много “медицинских туристов” из-за рубежа. Работа с ними организована так, что нет очередей, все процедуры больной проходит за короткое время, в комфортных условиях.
-
Виктория Николаевна
Лучшие хирурги Израиля, как мне кажется, работают в Ихилов. Столько операций, как здесь, наверное, не проводится больше нигде. В онкоцентре при клинике Ихилов одновременно лечатся сотни человек.
-
- Крупнейшая гос. больница г.Хайфа
- Выбранный доктор не гарантирован
- Более 30 отделений
- Отделение гематонкологии
-
Оценка: 8.2Отправить запрос
- Описание
- Отзывы
- Врачи
-
Екатерина Д.
Болею раком шейки матки 2 стадии. Понятно, что операции и облучения не избежать, но я не хотела всю жизнь потом принимать гормоны. На консультации мне сказали, что при операции яичники будут перемещены вверх, и облучение их не заденет, поэтому они не пострадают. Я очень благодарна врачам, за то что они учитывают все проблемы и пожелания больных.
-
Кристина
Что такое нано-нож?
-
Администратор02.09.2019
Это новейшая технология радикального лечения, принцип действия которого заключается в поражении опухоли мягких тканей электрическим током. Метод минимально повреждает близлежащие органы и сосуды.
-
-
Валентин Сергеевич
Очень большое преимущество клиники Рамбам - ее расположение в Хайфе, а не в Тель-Авиве. Поэтому цены на аренду жилья здесь ниже. Я проходил здесь чек-ап диагностику рака, а потом так понравилось, что остался отдохнуть на Средиземном море еще на неделю.
-
- Гос. больница
- Новейшее оборудование
- Быстрая диагностика
- Детское онкологическое отделение
-
Оценка: 8.2Отправить запрос
- Описание
- Отзывы
- Врачи
-
Вероника П.
Я не представляла, как сложно вылечить это заболевание, пока сама не столкнулась с этой бедой. У сына в 4 года диагностировали лейкоз. Мы сразу стали искать варианты лечения за границей и остановились на институте онкогематологии центра Бейлинсон. Поразило даже не оборудование и сложные процедуры, на все это я и рассчитывала. Но мне и сыну очень помогло доброе и внимательное отношение врачей и медсестер. После долгого лечения все показатели крови, наконец, пришли в норму, большое спасибо всем, кто помог моему ребенку справиться с болезнью.
-
Владимир
Есть ли у клиники гарантии, что поставленный диагноз верный?
-
Администратор13.10.2019
Диагностика и лечение, проводимые в клинике Бейлинсон, соответствуют современным мировым стандартам. Минздрав Израиля строго контролирует деятельность всех медучреждений страны. Ошибки практически исключены.
-
-
Ульяна У., г. Санкт-Петербург
В клинике Бейлинсон работает вежливый и доброжелательный персонал. Врачи поражают своим мастерством и профессионализмом. Израильская медицина – реально лучшая в мире.
-
- Частная клиника
- Возможен выбор доктора
- VIP обслуживание
- Качественная диагностика
-
Оценка: 8Отправить запрос
- Описание
- Отзывы
- Врачи
-
Лиана
Клиника сама по себе небольшая, почему она имеет такую хорошую репутацию?
-
Администратор01.10.2019
Одновременно здесь лечится не много пациентов. Однако это гарантирует тщательное обследование и индивидуальное лечение каждого случая. Клиника отлично оснащена диагностическим оборудованием, здесь развернуты современные операционные. Все это позволяет использовать передовые технологии и сокращать время пребывания пациента в стационаре. Кроме того, в больнице созданы максимально комфортные условия и VIP-палаты.
-
-
Михаил
Как получить визу на лечение?
-
Администратор03.04.2019
Если вы гражданин России или СНГ, сама виза не требуется. Наша клиника высылает вам официальное приглашение для прохождения лечения в Израиле.
-
-
- Профильный онкоцентр
- Государственная больница
- Детское отделение
- Отделение гематонкологии
-
Оценка: 8.1Отправить запрос
- Описание
- Отзывы
- Врачи
-
Аноним
Какие методы диагностики наиболее информативны при раке мозга?
-
Администратор04.11.2019
Наиболее эффективными исследованиями являются МРТ, КТ и ПЭТ-КТ. Чтобы выяснить, злокачественная ли опухоль или нет, применяется биопсия.
-
-
Екатерина
“Давидов” оснащен разнообразным оборудованием для лучевой терапии. Это дает врачам возможность подобрать для каждого пациента оптимальный метод облучения.
-
Роман Игоревич
В онкоцентре Давидов создано одно из лучших израильских отделений онкогематологии, где проводится лечение лейкозов у взрослых и детей, в том числе выполняется большое число трансплантаций костного мозга.
Отправить запрос в израильские онкоцентры
Вы получите программы лечения и стоимость из нескольких израильских клиник

Несколько лет беспокоила постоянная боль в лице, головные боли, половина лица постоянно немела. Дома назначали уколы, физиотерапию, но ничего не помогало. После лечения у доктора Шпигельмана боль прошла.
Рак желудка оперировала в клинике Ассута. Здесь работают лучшие врачи, которым не страшно доверить свою жизнь. Отдельное спасибо доктору Ирине Жевелюк.
Ассута - одна из лучших онкоклиники Израиля, а возможно, и всего мира. Здесь работают лучшие врачи, самые опытные, квалифицированные специалисты, которым не страшно доверить свое здоровье и жизнь.
В отличие от многих израильских клиник, в Ассуте можно выбрать лечащего врача, который специализируется на нужном заболевании или владеет необходимой методикой лечения.
Все отзывы